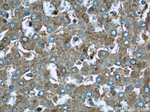
UQCRC1 Antibody in Immunohistochemistry (Paraffin) (IHC (P))

Search
Proteintech
UQCRC1 Polyclonal Antibody
{{$productOrderCtrl.translations['antibody.pdp.commerceCard.promotion.promotions']}}
{{$productOrderCtrl.translations['antibody.pdp.commerceCard.promotion.viewpromo']}}
{{$productOrderCtrl.translations['antibody.pdp.commerceCard.promotion.promocode']}}: {{promo.promoCode}} {{promo.promoTitle}} {{promo.promoDescription}}. {{$productOrderCtrl.translations['antibody.pdp.commerceCard.promotion.learnmore']}}
产品信息
21705-1-AP
种属反应
已发表种属
宿主/亚型
分类
类型
抗原
偶联物
形式
浓度
规格
纯化类型
保存液
内含物
保存条件
运输条件
产品详细信息
Immunogen sequence: SQIEKERDV ILREMQENDA SMRDVVFNYL HATAFQGTPL AQAVEGPSEN VRKLSRADLT EYLSTHYKAP RMVLAAAGGV EHQQLLDLAQ KHLGGIPWTY AEDAVPTLTP CRFTGSEIRH RDDALPFAHV AIAVEGPGWA SPDNVALQVA NAIIGHYDCT YGGGVHLSSP LASGAVANKL CQSFQTFSIC YAETGLLGAH FVCDRMKIDD MMFVLQGQWM RLCTSATESE VARGKNILRN ALVSHLDGTT PVCEDIGRSL LTYGRRIPLA EWESRIAEVD ASVVREICSK YIYDQCPAVA GYGPIEQLPD YNRIRSGMFW LRF (159-480 aa encoded by BC009586)
靶标信息
UQCRC1 encodes a product that is a component of the ubiquinol-cytochrome c reductase complex (complex III or cytochrome b-c1 complex), which is part of the mitochondrial respiratory chain. This protein may mediate formation of the complex between cytochromes c and c1.
仅用于科研。不用于诊断过程。未经明确授权不得转售。
生物信息学
蛋白别名: Complex III subunit 1; Core protein I; Cytochrome b-c1 complex subunit 1, mitochondrial; ubiquinol-cytochrome c reductase core protein 1; ubiquinol-cytochrome c reductase core protein I; Ubiquinol-cytochrome-c reductase complex core protein 1; unnamed protein product
基因别名: 1110032G10Rik; D3S3191; PKNPY; QCR1; UQCR1; UQCRC1
UniProt ID: (Human) B2R7R8, (Rat) Q68FY0, (Mouse) Q9CZ13
Entrez Gene ID: (Human) 7384, (Rat) 301011, (Mouse) 22273